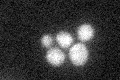
YOL006C
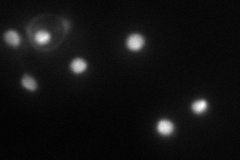
YOL006C
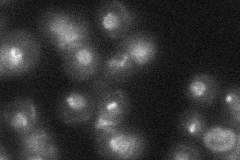
YOL006C
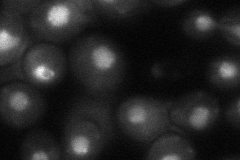
YOL006C

View description
Topoisomerase I, nuclear enzyme that relieves torsional strain in DNA by cleaving and re-sealing the phosphodiester backbone; relaxes both positively and negatively supercoiled DNA; functions in replication, transcription, and recombination
Localization:
Intensity:
Fold change:
Significance:
-
C’ GFP library in SD
cytosol18.84 -
N' NOP1pr-GFP in SD

punctate,nucleus74.4724 -
N' TEF2pr-mCherry in SD
nucleus74.9966 -
N' NATIVEpr-GFP in SD
nucleus,nucleolus26.3791 -
N' TEF2pr-VC and Cyto-VN in SD
punctate,nucleus48.987 -
C’ GFP library in SD+DTT

cytosol17.110.9No -
C’ GFP library in SD+H2O2

cytosol17.450.92No -
C’ GFP library in Starvation Media

cytosol16.870.89No -
C’ GFP library on the background of Pup2-DaMP

cytosol -
C’ GFP library on the background of CCT mutant

cytosol20.28771.07641No
